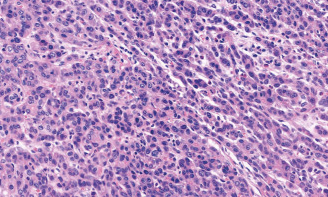
Επίχρισμα περιφερικού αίματος. Κόκκινο βέλοςs - Schistocytes. Πράσινο βέλος - Erythroblast (Ευγενική παραχώρηση Dr. V. Penopoulos)
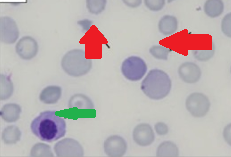
Κυψελιδική αιμορραγία (Ευγενική παραχώρηση Dr. V. Penopoulos)

Επείγοντα
116 εικόνες · 2 υποκατηγορίες

Εξερευνητική λαπαροτομία – Πολλαπλές διατρήσεις σε άλλο ασθενή με οζώδη πολυαρτηρίτιδα. Ευγενική παραχώρηση Dr. V. Penopoulos.

Εξερευνητική λαπαροτομία – Πολλαπλές διατρήσεις σε άλλο ασθενή με οζώδη πολυαρτηρίτιδα. Ευγενική παραχώρηση Dr. V. Penopoulos.

Αξονική τομογραφία οπισθοπεριτοναίου. Κίτρινα βέλη – Αμφοτερόπλευρη διάταση ουρητήρων. Ευγενική παραχώρηση Dr. V. Penopoulos.

Εξερευνητική λαπαροσκόπηση – Διατεταμένες, οιδηματώδεις έλικες λεπτού εντέρου με εστιακές περιοχές ισχαιμίας. Ευγενική παραχώρηση Dr. V. Penopoulos.

α) Νεκρωτική αγγειίτιδα. Διατοίχωμα φλεγμονή του αγγειακού τοιχώματος, με ή χωρίς ινοειδή νέκρωση. β) Νεκρωτική αγγειίτιδα μεσεντερικής αρτηρίας, με παναρτηριακή νέκρωση και παρουσία ινοειδούς νέκρωσης αγγειακού τοιχώματος. Ευγενική παραχώρηση Dr. V. Penopoulos.

Εξερευνητική λαπαροτομία – Πολλαπλές διατρήσεις σε άλλο ασθενή με οζώδη πολυαρτηρίτιδα. Ευγενική παραχώρηση Dr. V. Penopoulos.

Καρκινωματώδης λεμφαγγειΐτιδα. Εύρημα νεκροτομής (Ευγενική παραχώρηση Dr. V. Penopoulos)

Ινοβλαστική πολλαπλασίαση αγγειακού έσω χιτώνα, θρόμβωση, εμβολισμός από καρκινικά κύτταρα (Ευγενική παραχώρηση Dr. V. Penopoulos)

CT αγγειογραφία θώρακα. Κόκκινο βέλος - Έντονη διάταση της πνευμονικής αρτηρίας. Χωρίς ευρήματα πνευμονικής εμβολής (Ευγενική παραχώρηση Dr. V. Penopoulos)

Ανοσοϊστοχημική εξέταση. Εμβολισμός από καρκινικά κύτταρα (Ευγενική παραχώρηση Dr. V. Penopoulos)

Καρκινωματώδης λεμφαγγειΐτιδα. Εύρημα νεκροτομής (Ευγενική παραχώρηση Dr. V. Penopoulos)

Καρκινωματώδης λεμφαγγειΐτιδα. Εύρημα νεκροτομής (Ευγενική παραχώρηση Dr. V. Penopoulos)
Επίχρισμα περιφερικού αίματος. Κόκκινο βέλοςs - Schistocytes. Πράσινο βέλος - Erythroblast (Ευγενική παραχώρηση Dr. V. Penopoulos)

Κακώς διαφοροποιημένο καρκίνωμα στομάχου. Ιστοπαθολογική εξέταση (Ευγενική παραχώρηση Dr. V. Penopoulos)

CT θώρακα. Θολερές αναλαμπές τύπου «θαμπού υάλου» (Ευγενική παραχώρηση Dr. V. Penopoulos)

Καρδιακό υπερηχογράφημα. Διάταση δεξιάς κοιλίας, εύρημα ενδεικτικό πνευμονικής υπέρτασης (Ευγενική παραχώρηση Dr. V. Penopoulos)

ΗΚΓ. Αναστροφή κυμάτων T στις απαγωγές V1-V4, ενδεικτική καταπόνησης δεξιάς κοιλίας (Ευγενική παραχώρηση Dr. V. Penopoulos)

Καρκινωματώδης λεμφαγγειΐτιδα. Εύρημα νεκροτομής (Ευγενική παραχώρηση Dr. V. Penopoulos)

Ο κηλικός σάκος βρισκόταν μπροστά από τα μηριαία αγγεία (Ευγενική παραχώρηση Dr. V. Penopoulos).

Οισοφαγικό (πράσινο βέλος) και θωρακικής αορτής (κόκκινο βέλος) stent σε θέση (Ευγενική παραχώρηση Dr. V. Penopoulos)

CT θώρακος 6η μετεγχειρητική ημέρα: αυξημένη συσσώρευση αέρα στο μεσοθωρακικό αιμάτωμα (κόκκινα βέλη) (Ευγενική παραχώρηση Dr. V. Penopoulos)

CT θώρακος 3η μετεγχειρητική ημέρα: Αορτικό stent σε θέση (κόκκινο βέλος). Ελάχιστος αέρας στο μεσοθωρακικό αιμάτωμα (πράσινο βέλος) (Ευγενική παραχώρηση Dr. V. Penopoulos)

Τοποθετήθηκε προσθετική σφήνα πλέγματος στον μηριαίο σωλήνα (Ευγενική παραχώρηση Dr. V. Penopoulos).

Οισοφαγογράφημα που ανέδειξε διαρροή σκιαγραφικού από μέσο οισοφάγο στο μεσοθωράκιο (πράσινο βέλος). Αορτικό stent σε θέση (κόκκινο βέλος) (Ευγενική παραχώρηση Dr. V. Penopoulos)

Οισοφαγικό (πράσινο βέλος) και θωρακικής αορτής (κόκκινο βέλος) stent σε θέση (Ευγενική παραχώρηση Dr. V. Penopoulos)

Τα δύο σκέλη του σάκου απελευθερώθηκαν και ανυψώθηκαν (Ευγενική παραχώρηση Dr. V. Penopoulos).

Οισοφαγικό (πράσινο βέλος) και θωρακικής αορτής (κόκκινο βέλος) stent σε θέση (Ευγενική παραχώρηση Dr. V. Penopoulos)

Αγγειογραφία μετά εμβολισμό της αρτηρίας πλησίον του άπω άκρου του ψευδοανευρύσματος στο αρτηριακό τόξο του Riolan, που αποδεικνύει τα σπειράματα σε σωστή θέση. Απεικονίστηκαν οι σιγμοειδείς και η άνω ορθική αρτηρία, ενώ το ψευδοανεύρυσμα δεν ήταν ορατό (Ευγενική παραχώρηση Dr. V. Penopoulos)

Μεταεγχειρητικό CT. Σαφής μείωση αιματώματος. Χωρίς σημεία απόφραξης εντέρου ή εντερικής ισχαιμίας (Ευγενική παραχώρηση Dr. V. Penopoulos)

Αγγειογραφία μετά εμβολισμό της αρτηρίας πλησίον του άπω άκρου του ψευδοανευρύσματος στο αρτηριακό τόξο του Riolan, που αποδεικνύει τα σπειράματα σε σωστή θέση. Απεικονίστηκαν οι σιγμοειδείς και η άνω ορθική αρτηρία, ενώ το ψευδοανεύρυσμα δεν ήταν ορατό (Ευγενική παραχώρηση Dr. V. Penopoulos)

Αγγειογραφία μετά εμβολισμό της αρτηρίας πλησίον του άπω άκρου του ψευδοανευρύσματος στο αρτηριακό τόξο του Riolan, που αποδεικνύει τα σπειράματα σε σωστή θέση. Απεικονίστηκαν οι σιγμοειδείς και η άνω ορθική αρτηρία, ενώ το ψευδοανεύρυσμα δεν ήταν ορατό (Ευγενική παραχώρηση Dr. V. Penopoulos)

Αγγειογραφία μετά από εμβολή της αρτηρίας πλησίον του άπω άκρου του ψευδοανευρύσματος στο τόξο Riolan που δείχνει τα coils σε καλή θέση. Η σιγμοειδής αρτηρία και η άνω ορθική αρτηρία αναδείχθηκαν ενώ το ψευδοανεύρυσμα δεν αναδείχθηκε (Ευγενική παραχώρηση Dr. V. Penopoulos)

Μετεγχειρητική αξονική τομογραφία κοιλίας. Υποχώρηση αιματώματος. Απουσία σημείων εντερικής απόφραξης ή ισχαιμίας (Ευγενική παραχώρηση Dr. V. Penopoulos)

CT Αγγειογραφία. Πράσινο βέλος αιμάτωμα. Οριζόντιο κόκκινο βέλος stent στο AAA. Κατακόρυφο κόκκινο βέλος ψευδοανεύρυσμα τόξου Riolan (Ευγενική παραχώρηση Dr. V. Penopoulos)

Μετεγχειρητική αξονική τομογραφία κοιλίας. Υποχώρηση αιματώματος. Απουσία σημείων εντερικής απόφραξης ή ισχαιμίας (Ευγενική παραχώρηση Dr. V. Penopoulos)

Επιθηλιοειδή κακοήθη κύτταρα, με εμφανή κυτταρική ατυπία και μιτωτικές φιγούρες (Ευγενική παραχώρηση Dr. V. Penopoulos)

Αξονική τομογραφία κοιλίας – Θρόμβωση αριστερού κλάδου πυλαίας φλέβας. Ευγενική παραχώρηση Dr. V. Penopoulos.

Παροχετευμένη κοιλότητα αποστήματος – αφαίρεση νεκρωτικού υλικού. Ευγενική παραχώρηση Dr. V. Penopoulos.

Κόκκινο βέλος — Εκτοπισμένος όρχις στην αριστερή βουβωνική χώρα. Κίτρινο βέλος — Δεξιός όρχις εντός οσχέου (Ευγενική παραχώρηση Dr. V. Penopoulos)

Κόκκινο βέλος — Εκτοπισμένος όρχις στην αριστερή βουβωνική χώρα. Κίτρινο βέλος — Δεξιός όρχις εντός οσχέου (Ευγενική παραχώρηση Dr. V. Penopoulos)

Κόκκινο βέλος — Εκτοπισμένος όρχις στην αριστερή βουβωνική χώρα. Κίτρινο βέλος — Δεξιός όρχις εντός οσχέου (Ευγενική παραχώρηση Dr. V. Penopoulos)

Το αριστερό κάτω άκρο εμφανίζεται σαφώς μεγαλύτερο, παχύτερο, οιδηματώδες, με πολυάριθμες ορατές, έντονα διατεταμένες φλέβες (Ευγενική παραχώρηση Dr. V. Penopoulos)

Καθετηριασμός θωρακικού πόρου και ένεση κόλλας (Ευγενική παραχώρηση Dr. V. Penopoulos)

Διεγχειρητική άποψη (μετά από επιδιόρθωση διάτρησης ουροδόχου κύστης) (Ευγενική παραχώρηση Dr. V. Penopoulos)

Μετάσταση χολαγγειοκαρκινώματος σε σκελετικούς μύες (Ευγενική παραχώρηση Dr. V. Penopoulos)

Ομφαλική μετάσταση (Όζος αδελφής Μαρίας Ιωσήφ) (Ευγενική παραχώρηση Dr. V. Penopoulos)

Ψηλαφητές μεταστάσεις στον δεξιό λαγόνιο βόθρο (Ευγενική παραχώρηση Dr. V. Penopoulos)

Διεγχειρητική άποψη (μετά από επιδιόρθωση διάτρησης ουροδόχου κύστης) (Ευγενική παραχώρηση Dr. V. Penopoulos)

Διεγχειρητική άποψη (μετά από επιδιόρθωση διάτρησης ουροδόχου κύστης) (Ευγενική παραχώρηση Dr. V. Penopoulos)

Διεγχειρητική άποψη (μετά από επιδιόρθωση διάτρησης ουροδόχου κύστης) (Ευγενική παραχώρηση Dr. V. Penopoulos)

Αποκατάσταση χειρουργικού τραύματος. Το κεντρικό τμήμα αφέθηκε να επουλωθεί κατά δεύτερο σκοπό (Ευγενική παραχώρηση Dr. V. Penopoulos)

Ασυμμετρία χεριού και δακτύλων. Το αριστερό χέρι εμφανίζεται πιο παχύ και πιο μακρύ (Ευγενική παραχώρηση Dr. V. Penopoulos)

Μετάσταση χολαγγειοκαρκινώματος σε σκελετικούς μύες (Ευγενική παραχώρηση Dr. V. Penopoulos)

Ψηλαφητές μεταστάσεις στον δεξιό λαγόνιο βόθρο (Ευγενική παραχώρηση Dr. V. Penopoulos)

Καθετηριασμός θωρακικού πόρου και ένεση κόλλας (Ευγενική παραχώρηση Dr. V. Penopoulos)

Λεμφαγγειογραφία. Κόκκινο βέλος – Εστία βλάβης (Ευγενική παραχώρηση Dr. V. Penopoulos)

CT κοιλίας. Κόκκινο βέλος – Ασκίτης. Μοβ βέλος – Σπλήνας. Πράσινο βέλος – Ήπαρ (Ευγενική παραχώρηση Dr. V. Penopoulos)

CT κοιλίας. Μεταστατικές εστίες στους σκελετικούς μύες δεξιά (κόκκινα βέλη) (Ευγενική παραχώρηση Dr. V. Penopoulos)

Διεγχειρητική άποψη (μετά από επιδιόρθωση διάτρησης ουροδόχου κύστης) (Ευγενική παραχώρηση Dr. V. Penopoulos)

Μετάσταση χολαγγειοκαρκινώματος σε σκελετικούς μύες (Ευγενική παραχώρηση Dr. V. Penopoulos)

Αριστερός ημιθώρακας μεγαλύτερος από τον δεξιό (Ευγενική παραχώρηση Dr. V. Penopoulos)

Το αριστερό κάτω άκρο εμφανίζεται σαφώς μεγαλύτερο, παχύτερο, οιδηματώδες, με πολυάριθμες ορατές, έντονα διατεταμένες φλέβες (Ευγενική παραχώρηση Dr. V. Penopoulos)

Το αριστερό κάτω άκρο εμφανίζεται σαφώς μεγαλύτερο, παχύτερο, οιδηματώδες, με πολυάριθμες ορατές, έντονα διατεταμένες φλέβες (Ευγενική παραχώρηση Dr. V. Penopoulos)

Ενδοσκοπική εικόνα της θήκης. Παρουσία μεγάλων ποσοτήτων βλέννας και ψευδομεμβρανών (Ευγενική παραχώρηση Dr. V. Penopoulos)

Κίτρινο βέλος – Χολιτιδική ιλύς. Κόκκινο βέλος – Πάχυνση τοιχώματος χοληδόχου κύστης (Ευγενική παραχώρηση Dr. V. Penopoulos)

Κίτρινο βέλος – Χολιτιδική ιλύς. Κόκκινο βέλος – Πάχυνση τοιχώματος χοληδόχου κύστης (Ευγενική παραχώρηση Dr. V. Penopoulos)

Ενδοσκοπική εικόνα της θήκης. Παρουσία μεγάλων ποσοτήτων βλέννας και ψευδομεμβρανών (Ευγενική παραχώρηση Dr. V. Penopoulos)

Πάχυνση τοιχώματος χοληδόχου κύστης και παρουσία χολιτιδικής ιλύος (Ευγενική παραχώρηση Dr. V. Penopoulos)

CT κοιλίας. Ρήξη του αριστερού νεφρικού παρεγχύματος και μεγάλου μεγέθους οπισθοπεριτοναϊκό αιμάτωμα
Οξεία Κοιλία
(0 εικόνες)Δεν υπάρχουν εικόνες σε αυτό το κεφάλαιο ακόμα.
Τραύματα
(0 εικόνες)Δεν υπάρχουν εικόνες σε αυτό το κεφάλαιο ακόμα.